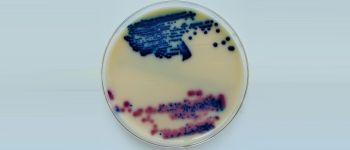
У нас новий антибіотик, і ми можемо створити його в лабораторії

Смертельний «супер грибок» може стати початком глобальної епідемії

Протигрибковий опір
Здатність бактерій розвивати стійкість до антибіотиків добре відома, але виявляється, що гриби також розвиваються, щоб протистояти сучасній медицині.
Тепер, згідно з тривожною історії The New York Times, один такий гриб з'являється в лікарнях по всій земній кулі й вбиває половину людей, які захворіли їм протягом 90 днів, що викликає стурбованість з приводу нової глобальної епідемії.
Глобальна загроза
Candida auris (C. auris) може заразити будь-якого, але люди з ослабленою імунною системою, такі як літні люди, найчастіше гинуть від грибка.
Лікарі тільки що виявили C. auris десять років тому в Японії. Але з того часу він виявився на всіх континентах, крім Антарктиди, з 587 випадками, зареєстрованими тільки в Сполучених Штатах.
«Ця істота з чорної лагуни», — сказав Таймс Чилер, глава грибного відділення Центрів з контролю над захворюваннями (CDC). «Це міхура, і тепер це всюди».
Стійкий патоген
Як тільки з'являється C. auris, позбутися від нього неймовірно складно.
За даними Times, CDC стверджує, що понад 90 відсотків інфекцій C. auris стійкі принаймні до одного основного протигрибковим препарату, а 30 відсотків — до двох або більше, і деякі медичні установи змушені були відвідувати такі установи. екстремальні довжини, такі як відривання плитки для підлоги й стелі для повного видалення слідів грибка з кімнати.
Джерела: The New York Times